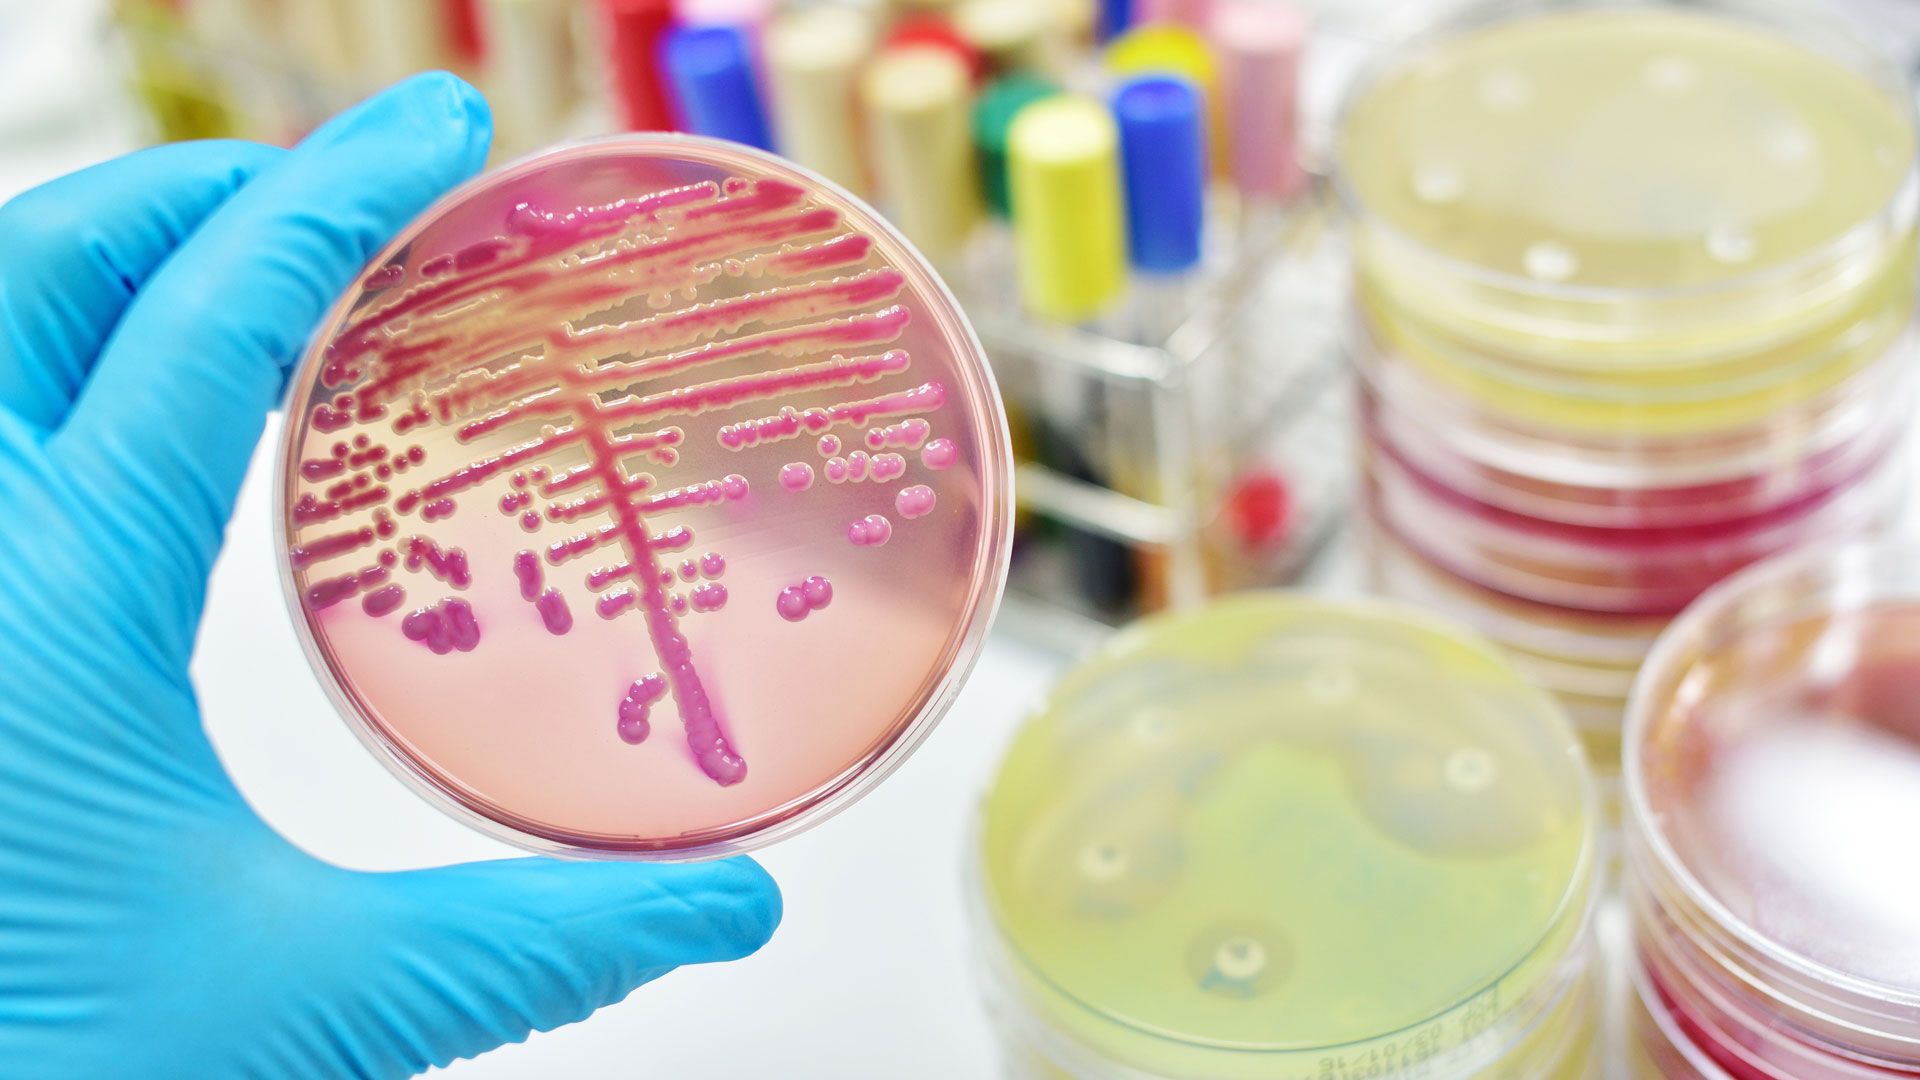
Bacterias Klebsiella oxytoca

Mucho cuidado con este lugar de la casa: se esconden bacterias resistentes a los antibióticos
Un hospital infantil hace un importante hallazgo que afecta a nuestros hábitos domésticos
Los patógenos resistentes a los antibióticos se pueden transmitir a través de lavadoras, según han certificado por primera vez higienistas de la Universidad de Bonn (Alemania) al descubrir que en un hospital infantil un tipo de Klebsiella oxytoca se transmitió repetidamente a los recién nacidos ingresados en una unidad de cuidados intensivos neonatales. La transmisión paró sólo cuando la lavadora fue retirada del hospital, según publica Applied and Environmental Microbiology, la revista de la Sociedad Americana de Microbiología.
"Este es un caso muy inusual para un hospital, ya que se trata de una lavadora de tipo doméstico. Los hospitales normalmente usan lavadoras especiales y procesos de lavado en los que se lava a altas temperaturas y con desinfectantes, de acuerdo con las pautas de higiene hospitalaria, o usan lavanderías externas designadas", explica la primera autora de la investigación, Ricarda M. Schmithausen.
"Los estudios ya han demostrado que las bacterias resistentes a los antibióticos pueden arraigarse en las lavadoras, pero nosotros hemos demostrado por primera vez que una lavadora también puede transmitir bacterias resistentes a los antibióticos a los humanos", señala el profesor Exner.

Por ello, esta investigación también tiene implicaciones para el uso doméstico de las lavadoras, advierte el doctor Schmithausen, médico del Instituto de Higiene y Salud Pública del Hospital Universitario de Bonn, un centro de colaboración de la OMS. Y es que las temperaturas del agua utilizadas en las lavadoras domésticas han disminuido, para ahorrar energía, a muy por debajo de 60°C, lo que las hace menos letales para los patógenos. Los genes de resistencia, así como los diferentes microorganismos, pueden persistir en las lavadoras domésticas a esas temperaturas reducidas, señalan los expertos.
"Si las personas mayores que requieren atención sanitaria con heridas abiertas o catéteres de vejiga, o personas más jóvenes con lesiones supurantes o infecciones viven en el hogar, la ropa debe lavarse a temperaturas más altas o con desinfectantes eficientes, para evitar la transmisión de patógenos peligrosos. Este es un reto cada vez mayor para los higienistas, ya que el número de personas que reciben cuidados de enfermería por parte de familiares aumenta constantemente", destaca Martin Exner, presidente y director del Instituto de Higiene y Salud Pública.
En el hospital donde la lavadora transmitía la K. oxytoca, los procedimientos de detección estándar revelaron la presencia de patógenos en los bebés en la UCI. Los investigadores finalmente rastrearon la fuente de los agentes patógenos hasta la lavadora, después de que no pudieran encontrar la contaminación en las incubadoras o encontrar transportadores entre los trabajadores de la salud que tuvieron contacto con los bebés.

Los recién nacidos estaban en la UCI debido principalmente a un parto prematuro o una infección no relacionada. La ropa que transmitía K. oxytoca de la lavadora a los bebés eran gorros y calcetines tejidos para ayudarlos a mantenerse calientes en las incubadoras, ya que los recién nacidos pueden enfriarse rápidamente, incluso en incubadoras, explica el doctor Exner.
Aún no está claro cómo y a través de qué fuente los patógenos ingresaron a la lavadora y, afortunadamente, los bebés de la UCI fueron colonizados pero no infectados por 'K. oxytoca'.
Los investigadores suponen que los patógenos "se diseminaron a la ropa después del proceso de lavado, a través del agua residual en el cierre de goma de la lavadora y/o a través del proceso de aclarado final, que hizo correr agua sin calentar y sin detergente a través del compartimento de detergente", según el informe.
Por ello, el estudio destaca que se requieren cambios en el diseño y el procesamiento de las lavadoras para evitar la acumulación de agua residual donde el crecimiento microbiano puede ocurrir y contaminar la ropa.
El tipo de resistencia a múltiples fármacos en la 'K. oxytoca' es causado por betalactamasas de espectro extendido (BLEE). Estas enzimas desactivan los antibióticos llamados betalactámicos. Los tipos más comunes de bacterias productoras de BLEE son Escherichia coli y bacterias del género Klebsiella.
